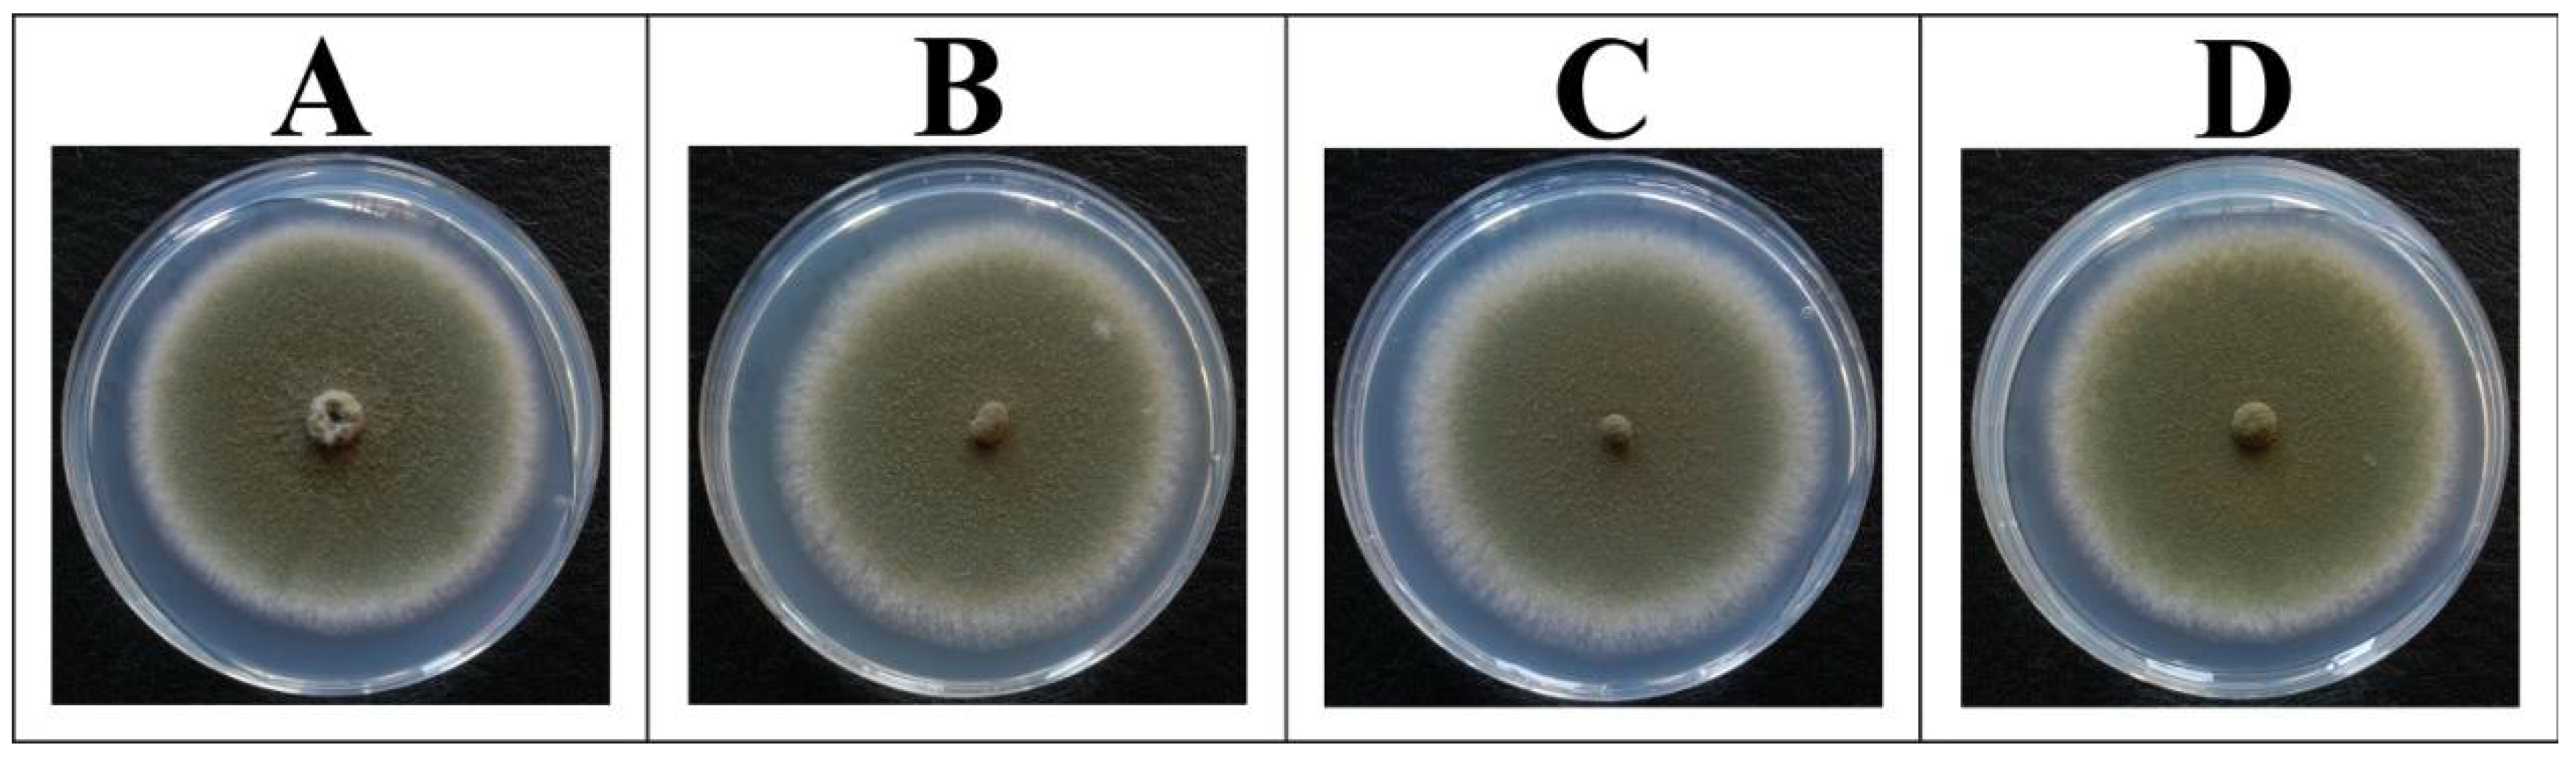
Toxins 10 00168 g003

Analysis of the Relationship between Alternative Respiration and Sterigmatocystin Formation in Aspergillus nidulans
Abstract
1. Introduction
2. Results
2.1. Verification of the Experimental Strategy
2.2. Biomass Formation of A. nidulans Is Independent of the aodA Copy Number
2.3. Alternative Oxidase Activity in the Late Stationary Phase of Growth
2.4. Sterigmatocystin Formation in A. nidulans Is Dependent on the aodA Copy Number, but Only in the Absence of Light
3. Discussion
4. Conclusions
5. Materials and Methods
5.1. Fungal Strains, Media, and Culture Conditions
5.2. Classical Genetic Techniques and Transformation
5.3. Genomic DNA Isolation and Southern Blot Analysis
5.4. Generation of Knockout Mutant Strains
5.5. Reintroduction of aodA into Gene-Deleted Backgrounds
5.6. Analytical Methods
5.7. Reproducibility
Supplementary Materials
Acknowledgments
Author Contributions
Conflicts of Interest
References
- Bendall, D.S.; Bonner, W.D. Cyanide-insensitive respiration in plant mitochondria. Plant Physiol. 1971, 47, 236–245. [Google Scholar] [CrossRef] [PubMed]
- Lambowitz, A.M.; Sabourin, M.; Bertrand, J.R.; Nickels, H.; McIntosh, R.L. Immunological identification of the alternative oxidase of Neurospora crassa mitochondria. Mol. Cell. Biol. 1989, 9, 1362–1364. [Google Scholar] [CrossRef] [PubMed]
- Siedow, J.N.; Umbach, A.L. Plant mitochondrial electron transfer and molecular biology. Plant Cell 1995, 7, 821–831. [Google Scholar] [CrossRef] [PubMed]
- Joseph-Horne, T.; Hollomon, D.W.; Wood, P.M. Fungal respiration: A fusion of standard and alternative components. Biochim. Biophys. Acta 2001, 1504, 179–195. [Google Scholar] [CrossRef]
- Tudella, V.G.; Curti, C.; Soriani, F.M.; Santos, A.C.; Uyemura, S.A. In situ evidence of an alternative oxidase and an uncoupling protein in the respiratory chain of Aspergillus fumigatus. Int. J. Biochem. Cell Biol. 2004, 36, 162–172. [Google Scholar] [CrossRef]
- McDonald, A.E.; Vanlerberghe, G.C.; Staples, J.F. Alternative oxidase in animals: Unique characteristics and taxonomic distribution. J. Exp. Biol. 2009, 212, 2627–2634. [Google Scholar] [CrossRef] [PubMed]
- Del-Saz, N.F.; Ribas-Carbo, M.; McDonald, A.E.; Lambers, H.; Fernie, A.R.; Florez-Sarasa, I. An in vivo perspective of the role(s) of the alternative oxidase. Trends Plant Sci. 2018, 23, 206–219. [Google Scholar] [CrossRef] [PubMed]
- Vanlerberghe, G.C.; McIntosh, L. Alternative oxidase: From gene to function. Ann. Rev. Plant Physiol. Plant Mol. Biol. 1997, 48, 703–734. [Google Scholar] [CrossRef] [PubMed]
- Tanton, L.L.; Nargang, C.E.; Kessler, K.E.; Li, Q.; Nargang, F.E. Alternative oxidase expression in Neurospora crassa. Fungal Genet. Biol. 2003, 39, 176–190. [Google Scholar] [CrossRef]
- Suzuki, Y.; Murray, S.L.; Wong, K.H.; Davis, M.A.; Hynes, M.J. Reprogramming of carbon metabolism by the transcriptional activators AcuK and AcuM in Aspergillus nidulans. Mol. Microbiol. 2012, 84, 942–964. [Google Scholar] [CrossRef] [PubMed]
- Hopwood, D.A.; Sherman, D.H. Molecular genetics of polyketides and its comparison to fatty acid biosynthesis. Annu. Rev. Genet. 1990, 24, 37–66. [Google Scholar] [CrossRef] [PubMed]
- Rank, C.; Nielsen, K.F.; Larsen, T.O.; Varga, J.; Samson, R.B.A.; Frisvad, J.S. Distribution of sterigmatocystin in filamentous fungi. Fungal Biol. 2011, 115, 406–420. [Google Scholar] [CrossRef] [PubMed]
- Wilkinson, H.H.; Ramaswamy, A.; Sung, C.S.; Keller, N.P. Increased conidiation associated with progression along the sterigmatocystin biosynthetic pathway. Mycology 2004, 96, 1190–1198. [Google Scholar] [CrossRef]
- Wogan, G.N. Aflatoxins as risk for hepatocellular carcinoma in humans. Cancer Res. 1992, 52, 2114–2118. [Google Scholar]
- Yabe, K.; Nakajima, H. Enzyme reactions and genes in aflatoxin biosynthesis. Appl. Microbiol. Biotechnol. 2004, 64, 745–755. [Google Scholar] [CrossRef] [PubMed]
- Klejnstrup, M.L.; Frandsen, R.J.N.; Holm, D.K.; Nielsen, M.T.; Mortensen, U.H.; Larsen, T.O.; Nielsen, J.B. Genetics of polyketide metabolism in Aspergillus nidulans. Metabolites 2012, 2, 100–133. [Google Scholar] [CrossRef] [PubMed]
- Barnes, S.E.; Dola, T.P.; Bennett, J.W.; Bhatnagar, D. Synthesis of sterigmatocystin on a chemically defined medium by species of Aspergillus and Chaetomium. Mycopathologia 1994, 125, 173–178. [Google Scholar] [CrossRef] [PubMed]
- Amaike, S.; Keller, N.P. Aspergillus flavus. Annu. Rev. Phytopathol. 2011, 49, 107–133. [Google Scholar] [CrossRef] [PubMed]
- Yu, J.; Chang, P.K.; Ehrlich, K.C.; Cary, J.W.; Bhatnagar, D.; Cleveland, T.E.; Payne, G.A.; Linz, J.E.; Woloshuk, C.P.; Bennett, J.W. Clustered pathway genes in aflatoxin biosynthesis. Appl. Environ. Microbiol. 2004, 70, 1253–1262. [Google Scholar] [CrossRef] [PubMed]
- Amaike, S.; Affeldt, K.J.; Yin, W.B.; Franke, S.; Choithani, A.; Keller, N.P. The bZIP protein MeaB mediates virulence attributes in Aspergillus flavus. PLoS ONE 2013, 8, 74030. [Google Scholar] [CrossRef] [PubMed]
- Németh, Z.; Molnár, Á.P.; Fejes, B.; Novák, L.; Karaffa, L.; Keller, N.P.; Fekete, E. Growth-phase sterigmatocystin formation on lactose is mediated via low specific growth rates in Aspergillus nidulans. Toxins 2016, 8, 354. [Google Scholar] [CrossRef] [PubMed]
- Brown, D.W.; Yu, J.H.; Kelkar, H.S.; Fernandes, M.; Nesbitt, T.C.; Keller, N.P.; Adams, T.H.; Leonard, T.J. Twenty-five coregulated transcripts define a sterigmatocystin gene cluster in Aspergillus nidulans. Proc. Natl. Acad. Sci. USA 1996, 93, 1418–1422. [Google Scholar] [CrossRef] [PubMed]
- Maggio-Hall, L.A.; Wilson, R.A.; Keller, N.P. Fundamental contribution of beta-oxidation to polyketide mycotoxin production in planta. Mol. Plant-Microbe Interact. 2005, 18, 783–793. [Google Scholar] [CrossRef] [PubMed]
- Keller, N.P.; Nesbitt, C.; Sarr, B.; Phillips, T.D.; Burow, G.B. pH regulation of sterigmatocystin and aflatoxin biosynthesis in Aspergillus spp. Phytopathology 1997, 87, 643–648. [Google Scholar] [CrossRef] [PubMed]
- Kato, N.; Brooks, W.; Calvo, A.M. The expression of sterigmatocystin and penicillin genes in Aspergillus nidulans is controlled by veA, a gene required for sexual development. Eukaryot. Cell 2003, 2, 1178–1186. [Google Scholar] [CrossRef] [PubMed]
- Klich, M.A. Aspergillus flavus: The major producer of aflatoxin. Mol. Plant Pathol. 2007, 8, 713–722. [Google Scholar] [CrossRef] [PubMed]
- Atoui, A.; Kastner, C.; Larey, C.M.; Thokala, R.; Etxebeste, O.; Espeso, E.A.; Fischer, R.; Calvo, A.M. Cross-talk between light and glucose regulation controls toxin production and morphogenesis in Aspergillus nidulans. Fungal Genet. Biol. 2010, 47, 962–972. [Google Scholar] [CrossRef] [PubMed]
- Bayram, Ö.; Feussner, K.; Dumkow, M.; Herrfurth, C.; Feussner, I.; Braus, G.H. Changes of global gene expression and secondary metabolite accumulation during light-dependent Aspergillus nidulans development. Fungal Genet. Biol. 2016, 87, 30–53. [Google Scholar] [CrossRef] [PubMed]
- Bayram, Ö.; Krappmann, S.; Ni, M.; Bok, J.W.; Helmstaedt, K.; Valerius, O.; Braus-Stromeyer, S.; Kwon, N.J.; Keller, N.P.; Yu, J.H.; et al. VelB/VeA/LaeA complex coordinates light signal with fungal development and secondary metabolism. Science 2008, 320, 1504–1506. [Google Scholar] [CrossRef] [PubMed]
- Kirimura, K.; Yoda, M.; Shimizu, H.; Sugano, S.; Mizuno, M.; Kino, K.; Usami, S. Contribution of cyanide-insensitive respiratory pathway, catalyzed by the alternative oxidase, to citric acid production in Aspergillus niger. Biosci. Biotechnol. Biochem. 2000, 64, 2034–2039. [Google Scholar] [CrossRef] [PubMed]
- Bahr, J.T.; Bonner, W.D. Cyanide insensitive respiration II. Control of the alternative pathway. J. Biol. Chem. 1973, 248, 3446–3450. [Google Scholar] [PubMed]
- Leiter, É.; Park, H.S.; Kwon, N.J.; Han, K.H.; Emri, T.; Oláh, V.; Mészáros, I.; Dienes, B.; Vincze, J.; Csernoch, L.; et al. Characterization of the aodA, dnmA, mnSOD and pimA genes in Aspergillus nidulans. Sci. Rep. 2016, 6, 20523. [Google Scholar] [CrossRef] [PubMed]
- Kern, A.; Hartner, F.S.; Freigassner, M.; Spielhofer, J.; Rumpf, C.; Leitner, L.; Fröhlich, K.U.; Glieder, A. Pichia pastoris ‘just in time’ alternative respiration. Microbiology 2007, 153, 1250–1260. [Google Scholar] [CrossRef] [PubMed]
- Luchese, R.H.; Harrigan, W.F. Biosynthesis of aflatoxin—The role of nutritional factors. J. Appl Bacteriol. 1993, 74, 5–14. [Google Scholar] [CrossRef] [PubMed]
- Morrice, J.; MacKenzie, D.A.; Parr, A.J.; Archer, D.B. Isolation and characterisation of the acetyl-CoA carboxylase gene from Aspergillus nidulans. Curr. Genet. 1998, 34, 379–385. [Google Scholar] [CrossRef] [PubMed]
- Fanelli, C.; Fabbri, A.A. Relationship between lipids and aflatoxin biosynthesis. Mycopathologia 1989, 107, 115–120. [Google Scholar] [CrossRef] [PubMed]
- Ma, H.; Zhang, N.; Sun, L.; Qi, D. Effects of different substrates and oils on aflatoxin B1 production by Aspergillus parasiticus. Eur. Food Res. Technol. 2015, 240, 627–634. [Google Scholar] [CrossRef]
- Kistler, H.C.; Broz, K. Cellular compartmentalization of secondary metabolism. Front. Microbiol. 2015, 6, 68. [Google Scholar] [CrossRef] [PubMed]
- Keller, N.P. Translating biosynthetic gene clusters into fungal armor and weaponry. Nat. Chem. Biol. 2015, 11, 671–677. [Google Scholar] [CrossRef] [PubMed]
- Brown, D.W.; Adams, T.H.; Keller, N.P. Aspergillus has distinct fatty acid synthases for primary and secondary metabolism. Proc. Natl. Acad. Sci. USA 1996, 93, 14873–14877. [Google Scholar] [CrossRef] [PubMed]
- Chavant, L.; Le Bars, J.; Sancholle, M. Metabolisme lipidique chez l’Aspergillus versicolor (Vuill.) Tiraboschi. Relations avec la biogenese de la sterigmatocystine. Mycopathologia 1977, 60, 151–155. [Google Scholar] [CrossRef] [PubMed]
- De Vries, R.P.; Riley, R.; Wiebenga, A.; Aguilar-Osorio, G.; Amillis, S.; Uchima, C.A.; Anderluh, G.; Asadollahi, M.; Askin, M.; Barry, K.; et al. Comparative genomics reveals high biological diversity and specific adaptations in the industrially and medically important fungal genus Aspergillus. Genome Biol. 2017, 18, 28. [Google Scholar] [CrossRef] [PubMed]
- Karaffa, L.; Sándor, E.; Kozma, J.; Kubicek, C.P.; Szentirmai, A. The role of the alternative respiratory pathway in the stimulation of cephalosporin C formation by soybean oil in Acremonium chrysogenum. Appl. Microbiol. Biotechnol. 1999, 51, 633–638. [Google Scholar] [CrossRef] [PubMed]
- Bovier, E.; Sellem, C.H.; Humbert, A.; Sainsard-Chanet, A. Genetic and functional investigation of Zn2Cys6 transcription factors RSE2 and RSE3 in Podospora anserina. Eukaryot. Cell 2014, 13, 53–65. [Google Scholar] [CrossRef] [PubMed]
- Chen, H.; Hao, G.; Wang, L.; Wang, H.; Gu, Z.; Liu, L.; Zang, H.; Chen, W.; Chen, Y.Q. Identification of a critical determinant that enables efficient fatty acid synthesis in oleaginous fungi. Sci. Rep. 2015, 5, 11247. [Google Scholar] [CrossRef] [PubMed]
- Wasylenko, T.M.; Ahn, W.S.; Stephanopoulos, G. The oxidative pentose phosphate pathway is the primary source of NADPH for lipid overproduction from glucose in Yarrowia lipolytica. Metab. Eng. 2015, 30, 27–39. [Google Scholar] [CrossRef] [PubMed]
- Sellem, C.H.; Bovier, E.; Lorin, S.; Sainsard-Chanet, A. Mutations in two zinc-cluster proteins activate alternative respiratory and gluconeogenic pathways and restore senescence in long-lived respiratory mutants of Podospora anserina. Genetics 2009, 182, 69–78. [Google Scholar] [CrossRef] [PubMed]
- Pérez-Sánchez, A.; Uribe-Carvajal, S.; Cabrera-Orefice, A.; Barrios-González, J. Key role of alternative oxidase in lovastatin solid-state fermentation. Appl. Microbiol. Biotechnol. 2017, 101, 7347–7356. [Google Scholar] [CrossRef] [PubMed]
- Fountain, J.C.; Bajaj, P.; Nayak, S.N.; Yang, L.; Pandey, M.K.; Kumar, V.; Jayale, A.S.; Chitikineni, A.; Lee, R.D.; Kemerait, R.C.; et al. Responses of Aspergillus flavus to oxidative stress are related to fungal development regulator, antioxidant enzyme, and secondary metabolite biosynthetic gene expression. Front. Microbiol. 2016, 7, 2048. [Google Scholar] [CrossRef] [PubMed]
- Kim, J.H.; Yu, J.; Mahoney, N.; Chan, K.L.; Molyneux, R.J.; Varga, J.; Bhatnagar, D.; Cleveland, T.E.; Nierman, W.C.; Campbell, B.C. Elucidation of the functional genomics of antioxidant-based inhibition of aflatoxin biosynthesis. Int. J. Food Microbiol. 2008, 122, 49–60. [Google Scholar] [CrossRef] [PubMed]
- Jayashree, T.; Subramanyam, C. Oxidative stress as a prerequisite for aflatoxin production by Aspergillus parasiticus. Free Radic. Biol. Med. 2000, 29, 981–985. [Google Scholar] [CrossRef]
- Narasaiah, K.V.; Sashidhar, R.B.; Subramanyam, C. Biochemical analysis of oxidative stress in the production of aflatoxin and its precursor intermediates. Mycopathologia 2006, 162, 79–89. [Google Scholar] [CrossRef] [PubMed]
- Reverberi, M.; Zjalic, S.; Ricelli, A.; Punelli, F.; Camera, E.; Fabbri, C.; Picardo, M.; Fanelli, C.; Fabbri, A.A. Modulation of antioxidant defense in Aspergillus parasiticus is involved in aflatoxin biosynthesis: A role for the ApyapA gene. Eukaryot. Cell 2008, 7, 988–1000. [Google Scholar] [CrossRef] [PubMed]
- Kenne, G.J.; Gummadidala, P.M.; Omebeyinje, M.H.; Mondal, A.M.; Bett, D.K.; McFadden, S.; Bromfield, S.; Banaszek, N.; Velez-Martinez, M.; Mitra, C.; et al. Activation of aflatoxin biosynthesis alleviates total ROS in Aspergillus parasiticus. Toxins 2018, 10, 57. [Google Scholar] [CrossRef] [PubMed]
- Roze, L.V.; Laivenieks, M.; Hong, S.Y.; Wee, J.; Wong, S.S.; Vanos, B.; Awad, D.; Ehrlich, K.C.; Linz, J.E. Aflatoxin biosynthesis is a novel source of reactive oxygen species—A potential redox signal to initiate resistance to oxidative stress? Toxins 2015, 7, 1411–1430. [Google Scholar] [CrossRef] [PubMed]
- Stinnett, S.M.; Espeso, E.A.; Cobeño, L.; Araújo-Bazán, L.; Calvo, A.M. Aspergillus nidulans VeA subcellular localization is dependent on the importin α carrier and on light. Mol. Microbiol. 2007, 63, 242–255. [Google Scholar] [CrossRef] [PubMed]
- Palmer, J.M.; Theisen, J.M.; Duran, D.M.; Grayburn, W.S.; Calvo, A.M.; Keller, N.P. Secondary metabolism and development is mediated by LlmF control of VeA subcellular localization in Aspergillus nidulans. PLoS Genet. 2013, 9, 1003193. [Google Scholar] [CrossRef] [PubMed]
- Bennett, J.W.; Dunn, J.J.; Goldsman, C.I. Influence of white light on production of aflatoxins and anthraquinones in Aspergillus parasiticus. Appl. Environ. Microbiol. 1981, 41, 488–491. [Google Scholar] [PubMed]
- Pontecorvo, G.; Roper, J.A.; Hemmons, L.M.; MacDonald, K.D.; Bufton, A.W.J. The genetics of Aspergillus nidulans. Adv. Genet. 1953, 5, 141–238. [Google Scholar] [PubMed]
- Shaaban, M.I.; Bok, J.W.; Lauer, C.; Keller, N.P. Suppressor mutagenesis identifies a velvet complex remediator of Aspergillus nidulans secondary metabolism. Eukaryot. Cell 2010, 9, 1816–1824. [Google Scholar] [CrossRef] [PubMed]
- Doyle, M.P.; Marth, E.H. Aflatoxin is degraded by mycelia from toxigenic and nontoxigenic strains of aspergilli grown on different substrates. Mycopathologia 1978, 63, 145–153. [Google Scholar] [CrossRef] [PubMed]
- Zhang, W.; Xue, B.; Li, M.; Mu, Y.; Chen, Z.; Li, J.; Shan, A. Screening a strain of Aspergillus niger and optimization of fermentation conditions for degradation of aflatoxin B₁. Toxins 2014, 6, 3157–3172. [Google Scholar] [CrossRef] [PubMed]
- Fekete, E.; Karaffa, L.; Sándor, E.; Seiboth, B.; Bíró, S.; Szentirmai, A.; Kubicek, C.P. Regulation of the intracellular beta-galactosidase activity of Aspergillus nidulans. Arch. Microbiol. 2002, 179, 7–14. [Google Scholar] [CrossRef] [PubMed]
- Kozma, J.; Karaffa, L. Effect of oxygen on the respiratory system and cephalosporin-C production in Acremonium chrysogenum. J. Biotechnol. 1996, 48, 59–66. [Google Scholar] [CrossRef]
- Clutterbuck, A.J. Aspergillus nidulans. In Handbook of Genetics, Bacteria, Bacteriophages, and Fungi; King, R.C., Ed.; Plenum Press: New York, NY, USA, 1974; Volume 1, pp. 447–510. [Google Scholar]
- Fekete, E.; Orosz, A.; Kulcsár, L.; Kavalecz, N.; Flipphi, M.; Karaffa, L. Characterization of a second physiologically relevant lactose permease gene (lacpB) in Aspergillus nidulans. Microbiology 2016, 162, 837–847. [Google Scholar] [CrossRef] [PubMed]
- Yu, J.H.; Hamari, Z.; Han, K.H.; Seo, J.A.; Reyes-Domínguez, Y.; Scazzocchio, C. Double-joint PCR: A PCR-based molecular tool for gene manipulations in filamentous fungi. Fungal Genet. Biol. 2004, 41, 973–981. [Google Scholar] [CrossRef] [PubMed]
- Tilburn, J.; Scazzocchio, C.; Taylor, G.G.; Zabicky-Zissman, J.H.; Lockington, R.A.; Davies, R.W. Transformation by integration in Aspergillus nidulans. Gene 1983, 26, 205–221. [Google Scholar] [CrossRef]
- Nayak, T.; Szewczyk, E.; Oakley, C.E.; Osmani, A.; Ukil, L.; Murray, S.L.; Hynes, M.J.; Osmani, S.A.; Oakley, B.R. A versatile and efficient gene-targeting system for Aspergillus nidulans. Genetics 2006, 172, 1557–1566. [Google Scholar] [CrossRef] [PubMed]
- Kim, H.S.; Han, K.Y.; Kim, K.J.; Han, D.M.; Jahng, K.Y.; Chae, K.S. The veA gene activates sexual development in Aspergillus nidulans. Fungal Genet. Biol. 2002, 37, 72–80. [Google Scholar] [CrossRef]
- Bayram, Ö.; Braus, G.H. Coordination of secondary metabolism and development in fungi: The velvet family of regulatory proteins. FEMS Microbiol. Rev. 2012, 36, 1–24. [Google Scholar] [CrossRef] [PubMed]
- Lambowitz, A.M.; Slayman, C.W. Cyanide-resistant respiration in Neurospora crassa. J. Bacteriol. 1971, 108, 1087–1096. [Google Scholar] [PubMed]

| Time (h) | Wild-Type | aodA Deletant | aodA+ 2 Copies | aodA+ 3 Copies | |
|---|---|---|---|---|---|
| Total respiration (μM O2 min−1 gDCW−1) | 24 90 | 20.7 ± 0.7 8.5 ± 0.3 | 19.4 ± 0.5 8.4 ± 0.5 | 25.4 ± 1.0 5.4 ± 0.2 | 30.6 ± 1.1 5.0 ± 0.1 |
| Cyanide-resistant respiration (μM O2 min−1 gDCW−1) | 24 90 | 4.4 ± 0.2 3.4 ± 0.4 | 0.8 ± 0.1 0.4 ± 0.1 | 9.1 ± 0.3 3.9 ± 0.4 | 12.8 ± 0.5 4.3 ± 0.4 |
| Cyanide-resistant fraction (%) | 24 90 | 21.2 40.0 | 4.1 4.7 | 35.8 72.2 | 41.8 86.0 |
| Fungal Strain | Glucose Utilization Rate (g h−1) | Growth Rate (gDCW h−1) |
|---|---|---|
| Reference (RDIT 9.32) | 0.31± 0.03 | 0.15 ± 0.02 |
| aodA deletant (AMZN 3.37) | 0.29 ± 0.03 | 0.14 ± 0.02 |
| aodA+, 2 copies (AMZN 4.7) | 0.37 ± 0.03 | 0.15 ± 0.01 |
| aodA+, 3 copies (AMZN 5.13) | 0.44 ± 0.03 | 0.15 ± 0.02 |
© 2018 by the authors. Licensee MDPI, Basel, Switzerland. This article is an open access article distributed under the terms and conditions of the Creative Commons Attribution (CC BY) license (http://creativecommons.org/licenses/by/4.0/).
Share and Cite
Molnár, Á.P.; Németh, Z.; Fekete, E.; Flipphi, M.; Keller, N.P.; Karaffa, L. Analysis of the Relationship between Alternative Respiration and Sterigmatocystin Formation in Aspergillus nidulans. Toxins 2018, 10, 168. https://doi.org/10.3390/toxins10040168
Molnár ÁP, Németh Z, Fekete E, Flipphi M, Keller NP, Karaffa L. Analysis of the Relationship between Alternative Respiration and Sterigmatocystin Formation in Aspergillus nidulans. Toxins. 2018; 10(4):168. https://doi.org/10.3390/toxins10040168
Chicago/Turabian StyleMolnár, Ákos P., Zoltán Németh, Erzsébet Fekete, Michel Flipphi, Nancy P. Keller, and Levente Karaffa. 2018. "Analysis of the Relationship between Alternative Respiration and Sterigmatocystin Formation in Aspergillus nidulans" Toxins 10, no. 4: 168. https://doi.org/10.3390/toxins10040168
APA StyleMolnár, Á. P., Németh, Z., Fekete, E., Flipphi, M., Keller, N. P., & Karaffa, L. (2018). Analysis of the Relationship between Alternative Respiration and Sterigmatocystin Formation in Aspergillus nidulans. Toxins, 10(4), 168. https://doi.org/10.3390/toxins10040168

